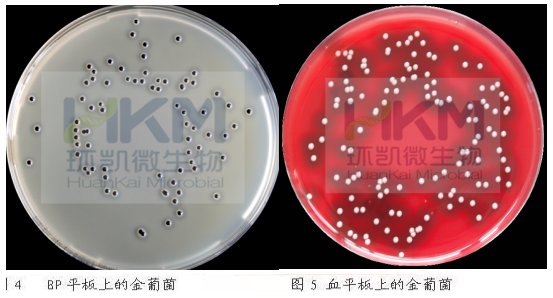

-

食品接触面风险与控制解决方案
环凯为食品接触面清洁卫生的微生物检测提供的整套解决方案,通过微生物检测加以验证,根据验证结果动态调整计划或方案,可以达到既节约企业成本又提高食品接触面清洁卫生有效性的目的,为企业生产出安全卫生健康的产品保驾护航。
2018-07-10 -

粽子食品微生物检测方案
为保障端午节期间人民群众能够吃到安全放心的粽子,各地食药局每年都会在端午节前进行粽子抽检,保障民众食用安全。由此,环凯公司列出粽子食品微生物检测专项检测推荐方案,助于开展监督检测工作,提高检测工作的高效性,便利性,及检测的准确性。保障粽子质量安全,为食品安全,保驾护航。
2018-06-04 -

湿式餐具大肠菌群检验纸片检验应用实例
环凯自主研发生产的干式餐具大肠菌群检验纸片,以经济、方便、快捷等优点给检验工作带来很大的便利。为了让用户使用纸片法检验餐具大肠菌群更加便捷,环凯在原有干式大肠菌群检验纸片的基础上进行改进,现推出开袋即用的湿式餐具大肠菌群检验纸片新产品。与干式餐具大肠菌群检验纸片相比,湿式餐具大肠菌群检验纸片开袋取出纸片直接贴于采样点上即可,免采样前加水润湿纸片的操作,更加的省时省力!
2018-05-30 -
金黄色葡萄球菌检验解决方案
金黄色葡萄球菌在自然界中无处不在,空气、水、灰尘及人和动物的排泄物中都可找到。因此,食品受到污染的机会很多。美国疾病控制中心报告,由金黄色葡萄球菌引起的感染占第二位,仅次于大肠杆菌。金黄色葡萄球菌肠毒素是个世界性卫生难题,可以通过制备、增菌与分离培养、鉴定一系列流程检验样品中是否含有金黄色葡萄球菌。
2018-01-25 -

月饼微生物检测方案
每逢中秋节,月饼的质量安全就会成为人民高度关注的问题,担心月饼质量不过关。为保障中秋节期间人民群众能够吃到安全放心的月饼,各地食药局每年都会在中秋节期间进行月饼抽检,保障月饼安全。由此,环凯公司列出月饼食品微生物检测专项检测推荐方案,助于开展监督检测工作,提高检测工作的高效性,便利性,及检测的准确性。保障月饼质量安全,为食品安全,保驾护航。
2017-09-01 -

二氧化氯检测行业应用方案
随着二氧化氯消毒剂在供制水及食品饮料行业的广泛应用,涉及到二氧化氯的检测需求也日益增加,那么二氧化氯检测有什么特殊的地方吗?
2017-09-12 -

滤膜法在水中微生物检验中的四大必备仪器
滤膜法,是以微孔滤膜截留液体样品中的微生物,并直接在滤膜上进行培养的微生物检验方法;在国内外制药工业、环境监测、食品工业、等领域得到了广泛的应用。滤膜法的原理相对简单,所需用到的仪器数量也不多,但应用滤膜法必须用到四种必备的仪器。
2016-08-26 -

农药残留速测仪——保证百姓“菜篮子”安全的高效检测仪
据农业部讯,继2016年5月下旬,天津市财政专门拨款2000万元用于完善、支持放心菜基地快速检测市室的硬件建设日常运营后,广州市白云区食品药监局则对外公示称,该区109家农贸市场已全面开展自检验工作,其配备自检室、专职检测人员,每日均开展对“肉、菜、鱼”的快速检测,检测结果向消费者公开公示。从抽样、检测到数据上传,整个流程仅需3小时左右。
2016-08-26 -

多参数食品安全速测仪——食品安全快检的又一选择
食品安全问题是一个遍及全球的公共卫生问题,不仅直接关系到人类的健康生存,还是关系到国计民生、社会安定的大事。2015年10月1日,2015年最新修订的《食品安全法》正式实施,此法亦被称为迄今为止最严的食品法。食品安全问题被群众提高到一个新高度,传统食品安全检测方法已不适合现在快速检测节奏,应用食品安全检测技术迫在眉睫!
2016-08-26 -

CIP清洗剂在包装饮用水工业中的应用
包装饮用水工业中,通常会对源水进行一系列的水处理过程以除去铁锰等可能产生沉淀的物质,吸附可能含有的有害化学物质和异味,以达到改善口感,保持产品稳定的目的。但是,在水处理过程中,源水中带有的微生物、可见沉淀和大分子有机物会被截留
2015-01-29






